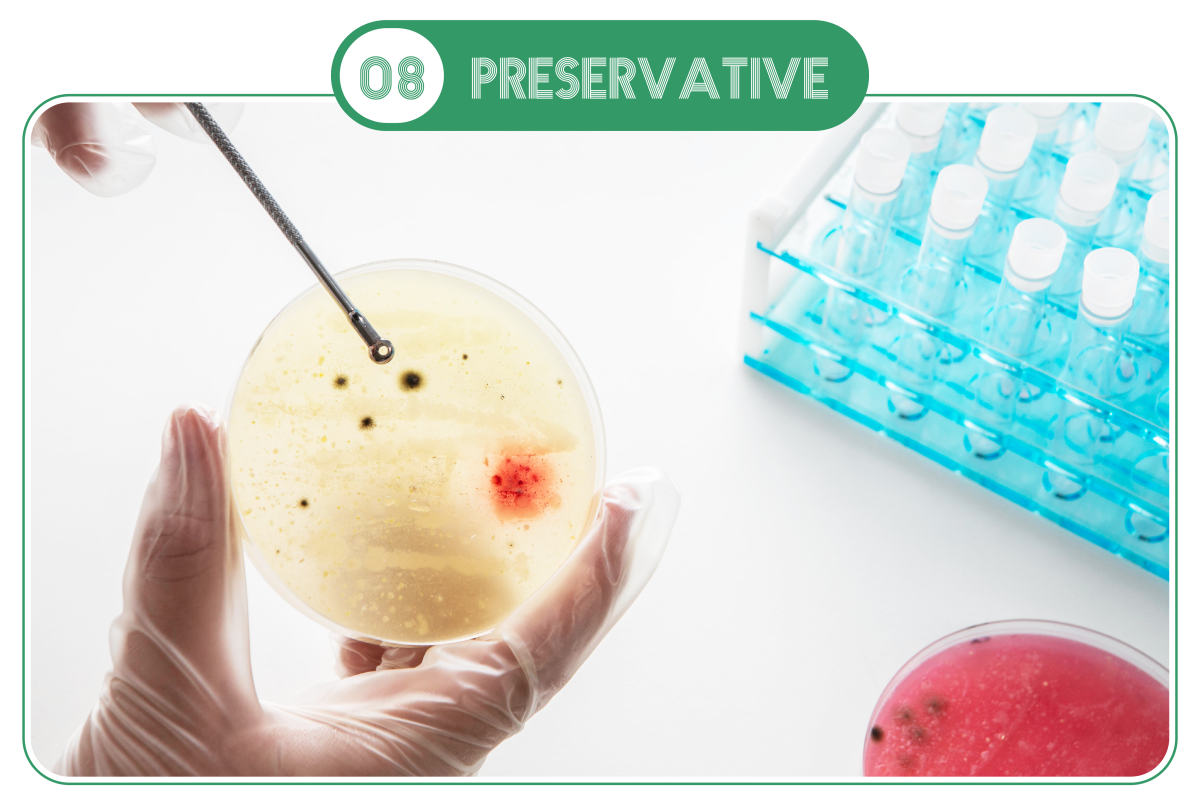

11 Ingredients ที่เป็นประเด็นกับความยั่งยืน

เครื่องสำอางยั่งยืน (Sustainable Cosmetics) เป็นกระแสในช่วง 10 ปีที่ผ่านมา แม้จะไม่ได้เป็นเทรนด์ที่ได้รับความนิยมอย่างต่อเนื่องแต่ก็ไม่เคยหายไปจากเทรนด์เครื่องสำอาง ด้วยสภาวะโลกที่ร้อนมากขึ้นและทรัพยากรที่มีอยู่ในโลกอย่างจำกัด ทำให้เครื่องสำอางเป็นอีกหนึ่งตัวเลือกที่จะยืนหยัดเพื่อความยั่งยืน ซึ่งมีหลายแบรนด์ที่เปลี่ยนส่วนผสมเครื่องสำอางที่ไม่ยั่งยืนให้ยั่งยืนและมีประสิทธิภาพที่ดีกับผู้ใช้ โดยส่วนผสมที่เป็นประเด็นในเรื่องความไม่ยั่งยืนมีดังนี้


ปิโตรลาทัม (petrolatum) และน้ำมันแร่ (mineral oil/ paraffinum liquidum) เป็นสารไฮโดรคาร์บอน มีคุณสมบัติให้ความชุ่มชื้นแก่ผิวหนัง (emollient) ทนทานต่อการเกิดออกซิเดชัน และอายุการเก็บรักษายาวนาน ได้มาจากกระบวนการปิโตรเคมี ใช้อย่างแพร่หลายในอุตสาหกรรมเครื่องสำอางเนื่องจากมีคุณสมบัติที่ดีกับผิวและราคาถูกกว่าน้ำมันให้ความชุ่มชื้นชนิดอื่น ๆ พบได้ในปิโตรเลียมเจลลี่ แชมพู ครีมนวดผม ทรีตเมนต์ ครีมลดเลือนริ้วรอย โลชั่น มาสคาร่า น้ำหอม ลิปสติก ลิปบาล์ม รองพื้น อายแชโดว์ สีทาเล็บ และครีมกันแดด
ปัญหาความยั่งยืนหลักเลยคือแหล่งกำเนิดมาจากปิโตรเคมี ปิโตรเคมีจะมีการขุดเอาน้ำมันดิบขึ้นมาแล้วกลั่นไปตามกระบวนการ ในกระบวนการมีการใช้น้ำในปริมาณมากและมีสารเคมีที่เป็นอันตรายซึ่งอาจส่งผลกระทบต่อแหล่งที่อยู่อาศัยของสัตว์น้ำและการปนเปื้อนในดินหากมีการรั่วไหลของน้ำมันทุกครั้งที่มีข่าวน้ำมันรั่วไหลในทะเลจะเห็นว่ามีผลกระทบมาก ๆ ต่อสัตว์น้ำและปะการังรวมไปถึงชายหาดที่กลายเป็นโคลนสีดำ กว่าระบบนิเวศจะฟื้นฟูกลับมาดีดังเดิมได้ก็ใช้เวลาหลายปี นอกจากนี้ คาร์บอนที่ได้จากปิโตรเคมียังสะสมอยู่ในชั้นบรรยากาศอย่างมาก ถูกจัดเป็นอันดับที่ 3 ของตัวการที่ปล่อยก๊าซเรือนกระจก ส่วนผสมทั้งปิโตรลาทัมและน้ำมันแร่เองก็นับว่าเป็นทรัพยากรที่ไม่สามารถหมุนเวียนได้อีกด้วย และหากทำการกลั่นสารออกมาได้ไม่ดีก็จะมีการปนเปื้อนสารเคมีที่เป็นพิษออกมาด้วยคือ polycyclic aromatic hydrocarbons (PAHs)
ส่วนผสมที่สามารถใช้ทดแทนได้ คือ กลุ่มน้ำมันจากพืช ซึ่งมีผลการวิจัยแล้วว่าให้ความชุ่มชื้นเทียบเท่าปิโตรลาทัมและน้ำมันแร่ เช่น castor oil, berry wax, sunflower oil, sweet almond oil, jojoba oil, shea butter, caprylic capric triglycerides (coconut origin), watermelon oil, lauryl oleate (sustainable palm oil (RSPO))

สควาเลน (squalane) ได้จากปฏิกิริยาไฮโดรจีเนชัน (hydrogenation) ของสควาลีน มีคุณสมบัติให้ความชุ่มชื้นแก่ผิวหนัง (emollient) และเสถียรกว่าสควาลีน แต่ด้วยสารตั้งต้นเป็นสควาลีนทำให้มีปัญหาความยั่งยืนคือ แหล่งที่มาของสควาลีนมาจากสัตว์ มีการแสวงหาผลประโยชน์จากสัตว์ด้วยการจับฉลามน้ำลึกมามากเกินไป ในปี 1910 มีการค้นพบสควาลีนในน้ำมันตับปลาฉลาม จากนั้นก็เริ่มมีการล่าฉลามมากขึ้นจนใกล้สูญพันธุ์ ทำให้ระบบนิเวศทางทะเลไม่สมดุล ฉลาม 3,000 ตัว ผลิตสวาลีนได้ไม่ถึง 1 ตันด้วยซ้ำ ในแต่ละปีมีฉลามที่ต้องตายถึง 2 ล้าน 7 แสนตัว เป็นจำนวนที่มากจนเกิดการวิพากษ์วิจารณ์ด้านสิ่งแวดล้อมขึ้นถึงได้มีการหยุดล่าฉลามแล้วหันมาใช้สควาลีนที่ได้จากพืชแทน พบได้ในผลิตภัณฑ์มอยส์เจอไรเซอร์ รองพื้น กันแดด ครีมนวดผม เป็นต้น
ส่วนผสมที่สามารถใช้ทดแทนได้ คือ สควาเลนที่มาจากพืชผักหรือจากการหมักจุลินทรีย์ โดยสควาเลนที่ได้จากพืชผักส่วนใหญ่จะมาจากผลพลอยได้จากการสกัดน้ำมันมะกอก แล้วนำไปทำให้ดีขึ้น (upcycling) จนได้สควาเลนจากน้ำมันมะกอกออกมา นอกจากนี้ เพื่อความยั่งยืนในอุตสาหกรรมเครื่องสำอางจึงได้มีการประยุกต์เทคโนโลยีสำหรับ engineering biology ขึ้นมาใช้ในการสกัดสควาเลน โดยการใช้พืชหมุนเวียนอย่างอ้อยมาหมักกับยีสต์ S. cerevisiae และใช้เทคโนโลยีในการหมัก ทำให้ได้สควาเลนที่บริสุทธิ์ เสถียร และมีประสิทธิภาพมากขึ้น

แอลกอฮอล์ไขมัน (fatty alcohol) เป็นสารไฮโดรคาร์บอนที่จับกับหมู่ไฮดรอกซิล มีหลากหลาย เช่น cetyl alcohol, stearyl alcohol, cetearyl alcohol, oleyl alcohol, behenyl alcohol, lanolin alcohol, caprylyl alcohol, decyl alcohol, isotearyl alcohol, lauryl alcohol, myristy alcohol, octyldodecanol มีคุณสมบัติให้ความชุ่มชื้นแก่ผิวหนัง (emollient) ช่วยให้สูตรคงตัว และเป็นส่วนผสมสำคัญสำหรับสารลดแรงตึงผิว (surfactant) พบได้ในผลิตภัณฑ์ให้ความชุ่มชื้น สบู่ก้อน สบู่เหลว ครีมเนื้อมุก ครีมนวดผม ทรีตเมนต์ กันแดด เป็นต้น แหล่งที่มามีทั้งพืชและสัตว์ ในแต่ละปีมีการผลิตแอลกอฮอล์ไขมันมากกว่า 1 ล้านตัน
ปัญหาความยั่งยืนที่เกิดขึ้นคือ แอลกอฮอล์ไขมันที่มาจากพืช เช่น ปาล์ม ถั่วเหลือง และมะพร้าว ได้มีการตัดไม้ทำลายป่าเพื่อเพาะปลูกพืชดังกล่าว ส่วนแหล่งที่มาจากสัตว์ เช่น โลมาและสเปิร์มวาฬ ทำให้มีการแสวงหาผลประโยชน์จากสัตว์เหล่านี้ นอกจากนี้ แหล่งที่มาอีกแห่งหนึ่งก็คือปิโตรเคมี มีการใช้โลหะหนักในปฏิกิริยาการสังเคราะห์ทางเคมี
ส่วนผสมที่สามารถใช้ทดแทนได้ คือ แอลกอฮอล์ไขมันที่ได้จากพืชที่มาจากการเกษตรแบบยั่งยืน ได้แก่ ปาล์ม (roundtable on sustainable palm oil (RSPO)) ถั่วเหลือง (round table on responsible soy (RTRS)) และมะพร้าว (sustainable coconut)

เอสเทอร์ (ester) เป็นสารประกอบมาจากปฎิกิริยาระหว่างแอลกอฮอล์กับกรดคาร์บอกซิลิหรือกรดไขมัน มีหลากหลาย เช่น isopropyl myristate, caprylic/capric triglyceride เป็นส่วนผสมอเนกประสงค์ในเครื่องสำอาง มีคุณสมบัติเป็นสารให้ความชุ่มชื้นผิวหนัง (emollient) สารออกฤทธิ์ (active) และสารอิมัลซิไฟเออร์ (emulsifier) แหล่งที่มามีทั้งพืช สัตว์ และสังเคราะห์ ปัญหาด้านความยั่งยืนในกลุ่มนี้คือ มีการแสวงหาผลประโยชน์จากสัตว์ การตัดไม้ทำลายป่า นอกจากนี้ กระบวนการผลิตต้องมีการทำปฏิกิริยา esterification ทำให้เกิดการสิ้นเปลืองพลังงาน
ส่วนผสมที่สามารถใช้ทดแทนได้ คือ สารทดแทนที่ทำจากปาล์มถูกกฎหมาย นวัตกรรมการผลิตเป็นมิตรกับสิ่งแวดล้อม ประหยัดพลังงานในการผลิต และมีประสิทธิภาพที่ดี เช่น bis-ethoxydiglycol cyclohexane 1,4-dicarboxylate, glyceryl caprylate/caprate, triethylhexanoin, ethylhexyl palmitate, polyglyceryl-10 decaisostearate, ethyl lactate, oleyl erucate

ซิลิโคน (Silicone) ถูกสังเคราะห์ขึ้นจากซิลิคอน ออกซิเจน และไฮโดรคาร์บอน และที่ใช้มากที่สุดในอุตสาหกรรมเครื่องสำอางคือ ซิลิโคนสายยาว (linear dimethicone) ช่วยลดความเหนียวเหนอะหนะและให้ความรู้สึกเรียบเนียนบนผิวหนัง และซิลิโคนแบบวง (cyclic cyclomethicone) สามารถระเหยได้อย่างรวดเร็ว ซิลิโคนบางตัวสามารถทนทานต่อการเกิดออกซิเดชันและความชื้น และสามารถเกลี่ยแพร่กระจายเป็นฟิล์มกันน้ำแต่ซึมผ่านได้ง่าย ใช้ในสูตรเครื่องสำอางได้เกือบทุกสูตร อย่างไรก็ตาม การใช้ซิลิโคนมีปัญหาด้านความยั่งยืนหลายประการ เป็นอันตรายต่อสิ่งแวดล้อมเพราะสามารถเกิดการสะสมได้ในสิ่งมีชีวิต โดยเฉพาะในระบบนิเวศทางน้ำ ในยุโรปมีการห้ามใช้ซิลิโคน D4 (Cyclomethicone) และ D5 (Cyclopentasiloxane) ในผลิตภัณฑ์แบบล้างออกตั้งแต่ปี 2020 เนื่องจากสารเคมีดังกล่าวส่งผลกระทบต่อสิ่งแวดล้อม สาร D4 ถูกจัดว่าเป็นสารตกต้างยาวนาน สะสมได้ในสิ่งมีชิวตและเป็นพิษ ขณะที่สาร D5 ถูกจัดว่าเป็นสารตกค้างยาวนานมาก และสะสมได้ในสิ่งมีชีวิต
ทางเลือกอื่นนอกจากซิลิโคน คือ ส่วนผสมที่ได้จากธรรมชาติ เช่น พอลิแซ็กคาไรด์ที่ได้จากพืช เชื้อรา และจุลินทรีย์ เช่น chitosan succinimide จากเห็ด และ carrageenan จากสาหร่ายสีแดง นอกจากนี้ ส่วนผสมอย่าง nonpolar alkane ก็เป็นอีกทางเลือกที่ใช้ทดแทนซิลิโคนได้ดี ผลิตจากปาล์มที่ยั่งยืน สามารถย่อยสลายได้ทางชีวภาพ และไม่เป็นพิษต่อสิ่งมีชีวิตในทะเล ยังมี undecane, tridecane, coco-caprylate ที่ให้สัมผัสดีเหมือนซิลิโคน แต่มาจากธรรมชาติและยั่งยืนกว่า

สารลดแรงตึงผิว (Surfactant) ทำหน้าที่ต่าง ๆ มากมายในสูตรเครื่องสำอาง ทั้งอิมัลซิไฟเออร์ ให้ความชุ่มชื้น ทำความสะอาด ช่วยกระจายตัว ช่วยละลาย เพิ่มประสิทธิภาพการซึมผ่าน เป็นต้น มี 4 ประเภท คือ anionic, cationic, nonionic และ amphoteric ตัวอย่างสารลดแรงตึงผิว เช่น sodium lauryl sulfate (SLS), ammonium lauryl sulfate (ALS), sodium laureth sulfate (SLES), alkyl benzene sulfonate, isethionates, acyl sarcosinate, isethionates, quaternary ammonium compounds (QAC) แหล่งที่มามีทั้งพืชและปิโตรเคมี
ปัญหาความยั่งยืนของสารลดแรงตึงผิว คือ มีการตกค้างของสาร ไม่สามารถย่อยสลายทางชีวภาพได้ และเป็นอันตรายต่อสิ่งมีชีวิตในทะเล นอกจากนี้ยังอาจทำให้เกิดอาการระคายเคืองผิวหนังได้ ทางเลือกที่ดีคือเปลี่ยนมาใช้สารลดแรงตึงผิวแบบไม่มีประจุ เช่น alkyl polyglucosides (APGs) เนื่องจากทำจากวัตถุดิบจากพืชหมุนเวียน 100% และสามารถย่อยสลายทางชีวภาพได้ง่าย นอกจากเป็นมิตรต่อสิ่งแวดล้อมแล้ว ยังมีความเป็นพิษต่ำ มีความอ่อนโยน และเข้ากันได้กับผิวหนังสูง

ตัวทำละลาย (solvent) ที่รู้จักส่วนมากมาจากปิโตรเลียม เช่น glycerine, propylene glycol และ butylene glycol มีคุณสมบัติให้ความชุ่มชื้นแต่ก็มีค่าความอุดตันผิวหนังที่สูง เสี่ยงเกิดสิวและอักเสบได้ง่าย และยังไม่ยั่งยืนอีกด้วย มีผลกระทบอย่างมากต่อมลภาวะต่อสิ่งแวดล้อมและมีส่วนทำให้เกิดการเปลี่ยนแปลงของสภาพภูมิอากาศ เพื่อความยั่งยืน
สามารถทดแทนด้วยตัวทำละลายอื่น ที่มีความยั่งยืนมากกว่า ผ่านกระบวนการเคมีสีเขียว มีความสามารถในการละลายและจุดวาบไฟสูง มีความเป็นพิษต่ำ ย่อยสลายได้ทางชีวภาพหรือรีไซเคิลได้ง่าย ได้มาจากแหล่งหมุนเวียน และมีราคาค่อนข้างถูก ตัวอย่างเช่น 1,3-propanediol ได้มาจากกากน้ำตาล เป็นผลพลอยได้จากการผลิตเชื้อเพลิงชีวภาพ ใช้พลังงานน้อย และผลิตก๊าซเรือนกระจกในปริมาณที่ต่ำกว่ามาก
สารกันเสีย (Preservative) ใส่ในสูตรเครื่องสำอางแทบทุกชนิด ช่วยยืดอายุผลิตภัณฑ์เครื่องสำอางให้นานขึ้นและป้องกันเชื้อจุลินทรีย์ก่อโรคในเครื่องสำอาง สารกันเสียที่เป็นที่รู้จักกันก็เช่น กลุ่ม parabens, phenoxyethanol, imidazolidinyl urea, diazolidinyl urea, methylisothiazolinone (MIT), methylchloroisothiazolinone (CMIT), butylated hydroxyanisole (BHA) และbutylated hydroxytoluene (BHT) เป็นสารกันเสียรุ่นโบราณที่มีมานานมากตั้งแต่สมัยก่อน มีประสิทธิภาพที่ดี ส่วนใหญ่มาจากการสังเคราะห์ และก่อให้เกิดปัญหาหลายประการ เช่น เป็นอันตรายต่อสุขภาพของคน อย่าง parabens เองก็มีการห้ามใช้ในบางตัว ส่วนตัวที่เหลือก็ถูกจำกัดปริมาณในการใช้
ปัจจุบันมีสารกันเสียที่หลายหลายขึ้นไม่เป็นอันตรายกับผิวหนัง และมาจากธรรมชาติ เช่น benzoic acid, sodium benzoate, sorbic acid, sodium sorbate, benzyl alcohol, salicylic acid หรือจะใช้เป็นสารสกัดจากพืชก็ได้เช่นกันแต่ต้องผ่านการทดสอบจุลชีพในเครื่องสำอางด้วยจึงจะใช้ได้

สารแต่งสี (Colorant) ใช้ในเครื่องสำอางเพื่อเพิ่มสีสันให้กับผลิตภัณฑ์เครื่องสำอาง ทำให้รูปลักษณ์ภายนอกดูดีขึ้น หรือเพื่อปกปิดสีผิว (รองพื้น) ให้ผมและเล็บมีสีสัน อาจเป็นสารสังเคราะห์หรือมาจากธรรมชาติก็ได้ มีทั้งแบบละลายน้ำและไม่ละลายน้ำ มีราคาถูก สีบางส่วนมาจากปิโตรเคมี แมลง และการทำเหมืองแร่ ทำให้เกิดปัญหาด้านสิ่งแวดล้อม การแสวงหาผลประโยชน์จากสัตว์ และความปลอดภัย
อุตสาหกรรมเครื่องสำอางจึงมีการค้นคว้าวิจัยสารแต่งสีจากธรรมชาติ ซึ่งสามารถย่อยสลายได้ทางชีวภาพ สามารถนำกลับมาใช้ใหม่ได้ และไม่เป็นพิษ และมีคุณสมบัติต่อต้านริ้วรอยแห่งวัยได้ด้วย เช่น สีที่มาจากแบคทีเรียอย่าง Bacillus, Achromobacter และ Brevibacterium หรือสีจากตะกอนทะเล

น้ำหอม (fragrances) เป็นโมเลกุลขนากเล็กที่ระเหยได้ ช่วยให้ผลิตภัณฑ์เครื่องสำอางมีกลิ่นหอม ผลิตได้จากพืช สัตว์ และสังเคราะห์ แม้จะใช้ในปริมาณต่ำแต่ก็สร้างปัญหาความยั่งยืนได้ น้ำหอมสามารถก่อให้เกิดมลพิษทางอากาศได้ และมีความสามารถในการย่อยสลายทางชีวภาพต่ำ นอกจากนี้ยังมีแนวโน้มที่จะทำให้เกิดอาการแพ้ทางผิวหนังได้ง่าย น้ำหอมสังเคราะห์เป็นน้ำหอมที่มีราคาถูกกว่าน้ำหอมจากธรรมชาติ และติดทนนานกว่า แต่สังเคราะห์มาจากปิโตรเคมี ส่วนที่สัดส่วนมาจากสัตว์เองก็ลดน้อยลงมากในปัจจุบัน เมื่อก่อนจะมีการสกัดสารหอมจากสัตว์อย่าง กวางมัสค์ แอมเบอร์กริสจากวาฬหลังค่อม และแคสโตเรียมจากบีเวอร์
ทางเลือกทดแทนคือใช้ธรรมชาติมาสกัดกลิ่น น้ำหอมจากพืชธรรมชาติจะถูกมองว่าเป็นมิตรกับสิ่งแวดล้อมมากกว่า ดีต่อสุขภาพ และมีการเกษตรแบบยั่งยืน เช่น ไร่ลาเวนเดอร์ ส้ม ไม้จันทน์ เป็นต้น

สารกรองรังสียูวี (UV filter) เครื่องสำอางหลายชนิดในท้องตลาดมีสารกรองรังสียูวีหรือสารกันแดดที่ช่วยปกป้องผู้ใช้จากอันตรายของรังสียูวี เช่น ผิวแก่แห่งวัย ผิวไหม้แดด ผิวคล้ำเสีย เป็นต้น แบ่งออกเป็น 2 ชนิด คือ กายภาพและเคมี สารกรองรังสียูวีแบบกายภาพ ได้แก่ titanium dioxzide ที่มาจากแร่ไทเทเนียม และ zinc oxide ที่มาจากแร่สังกะสี มีปัญหาด้านความยั่งยืนคือ มีการทำเหมืองแร่ที่ผิดกฎหมายและใช้แรงงานเด็ก ปัจจุบันการทำเหมืองมีความโปร่งใสมากขึ้น มีการรับรองถึงที่มาของส่วนผสมอย่างถูกต้อง ส่วนสารกรองรังสียูวีแบบเคมีจะมีปัญหาความยั่งยืนที่มากกว่าคือ ส่งผลกระทบต่อระบบนิเวศในทะเล ทำให้ปะการังฟอกขาวตายไปและเกิดการสะสมสารพิษในสัตว์น้ำ ในหลายประเทศจึงแก้ปัญหาด้วยการห้ามใช้สารกันแดดที่ส่งผลต่อปะการัง รวมถึงประเทศไทยด้วยที่มีการสั่งแบนสารกันแดด oxybenzone, octinoxate, 4-methylbenzylid camphor และ butylparaben
ทางเลือกที่ดีกว่าคือเปลี่ยนมาใช้สารกันแดดที่ไม่ส่งผลกระทบต่อสิ่งแวดล้อม หรือที่เรียกกันว่าสารกันแดดสีเขียว

เครื่องสำอางที่ยั่งยืนไม่เพียงแต่เป็นประโยชน์ต่อสิ่งแวดล้อมเท่านั้น แต่ยังช่วยให้แบรนด์สร้างภาพลักษณ์ที่ดี แบรนด์ที่คำนึงถึงความรับผิดชอบต่อสิ่งแวดล้อมและใส่ใจต่อสังคมมีแนวโน้มที่จะดึงดูดลูกค้ามากขึ้นโดยเฉพาะในกลุ่มคนรุ่นใหม่
TNP ขอนำเสนอ 4 แนวทางสู่การเป็นเครื่องสำอางรักษ์โลกแบบยั่งยืน ดังนี้
1. Clean & Green Labels
ข้อมูลและส่วนผสมบนฉลากมีความโปร่งใส ตรงไปตรงมา ข้อความหรือสัญลักษณ์ที่อ้างบนฉลากต้องได้รับการรับรอง เพื่อป้องกันการเอาเปรียบผู้บริโภค
2. Skinimalism
ผลิตภัณฑ์มีความเรียบง่าย ใช้ส่วนผสมในสูตรให้น้อยที่สุดเท่าที่จำเป็นเน้นคุณภาพมากกว่าปริมาณ เพื่อลดโอกาสการเกิดการระคายเคืองและอุดตัน
3. Sustainable Packaging
บรรจุภัณฑ์ที่ยั่งยืนต้องมีความรับผิดชอบต่อสิ่งแวดล้อม เช่น ใช้วัสดุอื่นทดแทนพลาสติก สามารถนำกลับมาใช้ใหม่ได้ และย่อยสลายได้ทางชีวภาพ ส่วนการรีฟิลก็เป็นอีกวิธีที่ช่วยลดปริมาณขยะได้เช่นกัน
4. Natural & Plant-Based Formulas
สูตรผลิตภัณฑ์มีความเป็นธรรมชาติ สามารถย่อยสลายได้ ไม่ส่งผลเสียต่อสิ่งแวดล้อมและสุขภาพในระยะยาว ส่วนผสมในสูตรมาจากแหล่งทรัพยากรที่ไม่กระทบต่อสิ่งแวดล้อม ชุมชน และท้องถิ่น
ที่มา
Martins, A. M., & Marto, J. M. (2023). A sustainable life cycle for cosmetics: From design and development to post-use phase. Sustainable Chemistry and Pharmacy, 35, 101178.
TNP ก็หวังว่าในอนาคตประเทศไทยจะก้าวเข้าสู่วงการเครื่องสำอางสีเขียวอย่างเต็มตัว เพื่อให้ธรรมชาติอยู่กับเราไปนาน ๆ สิ่งแวดล้อมที่ดีจะช่วยให้สุขภาพเราดีขึ้น
สร้างแบรนด์เครื่องสำอางรักษ์โลก ปรึกษาได้เลยค่ะ ครบ จบ พร้อมขาย!


